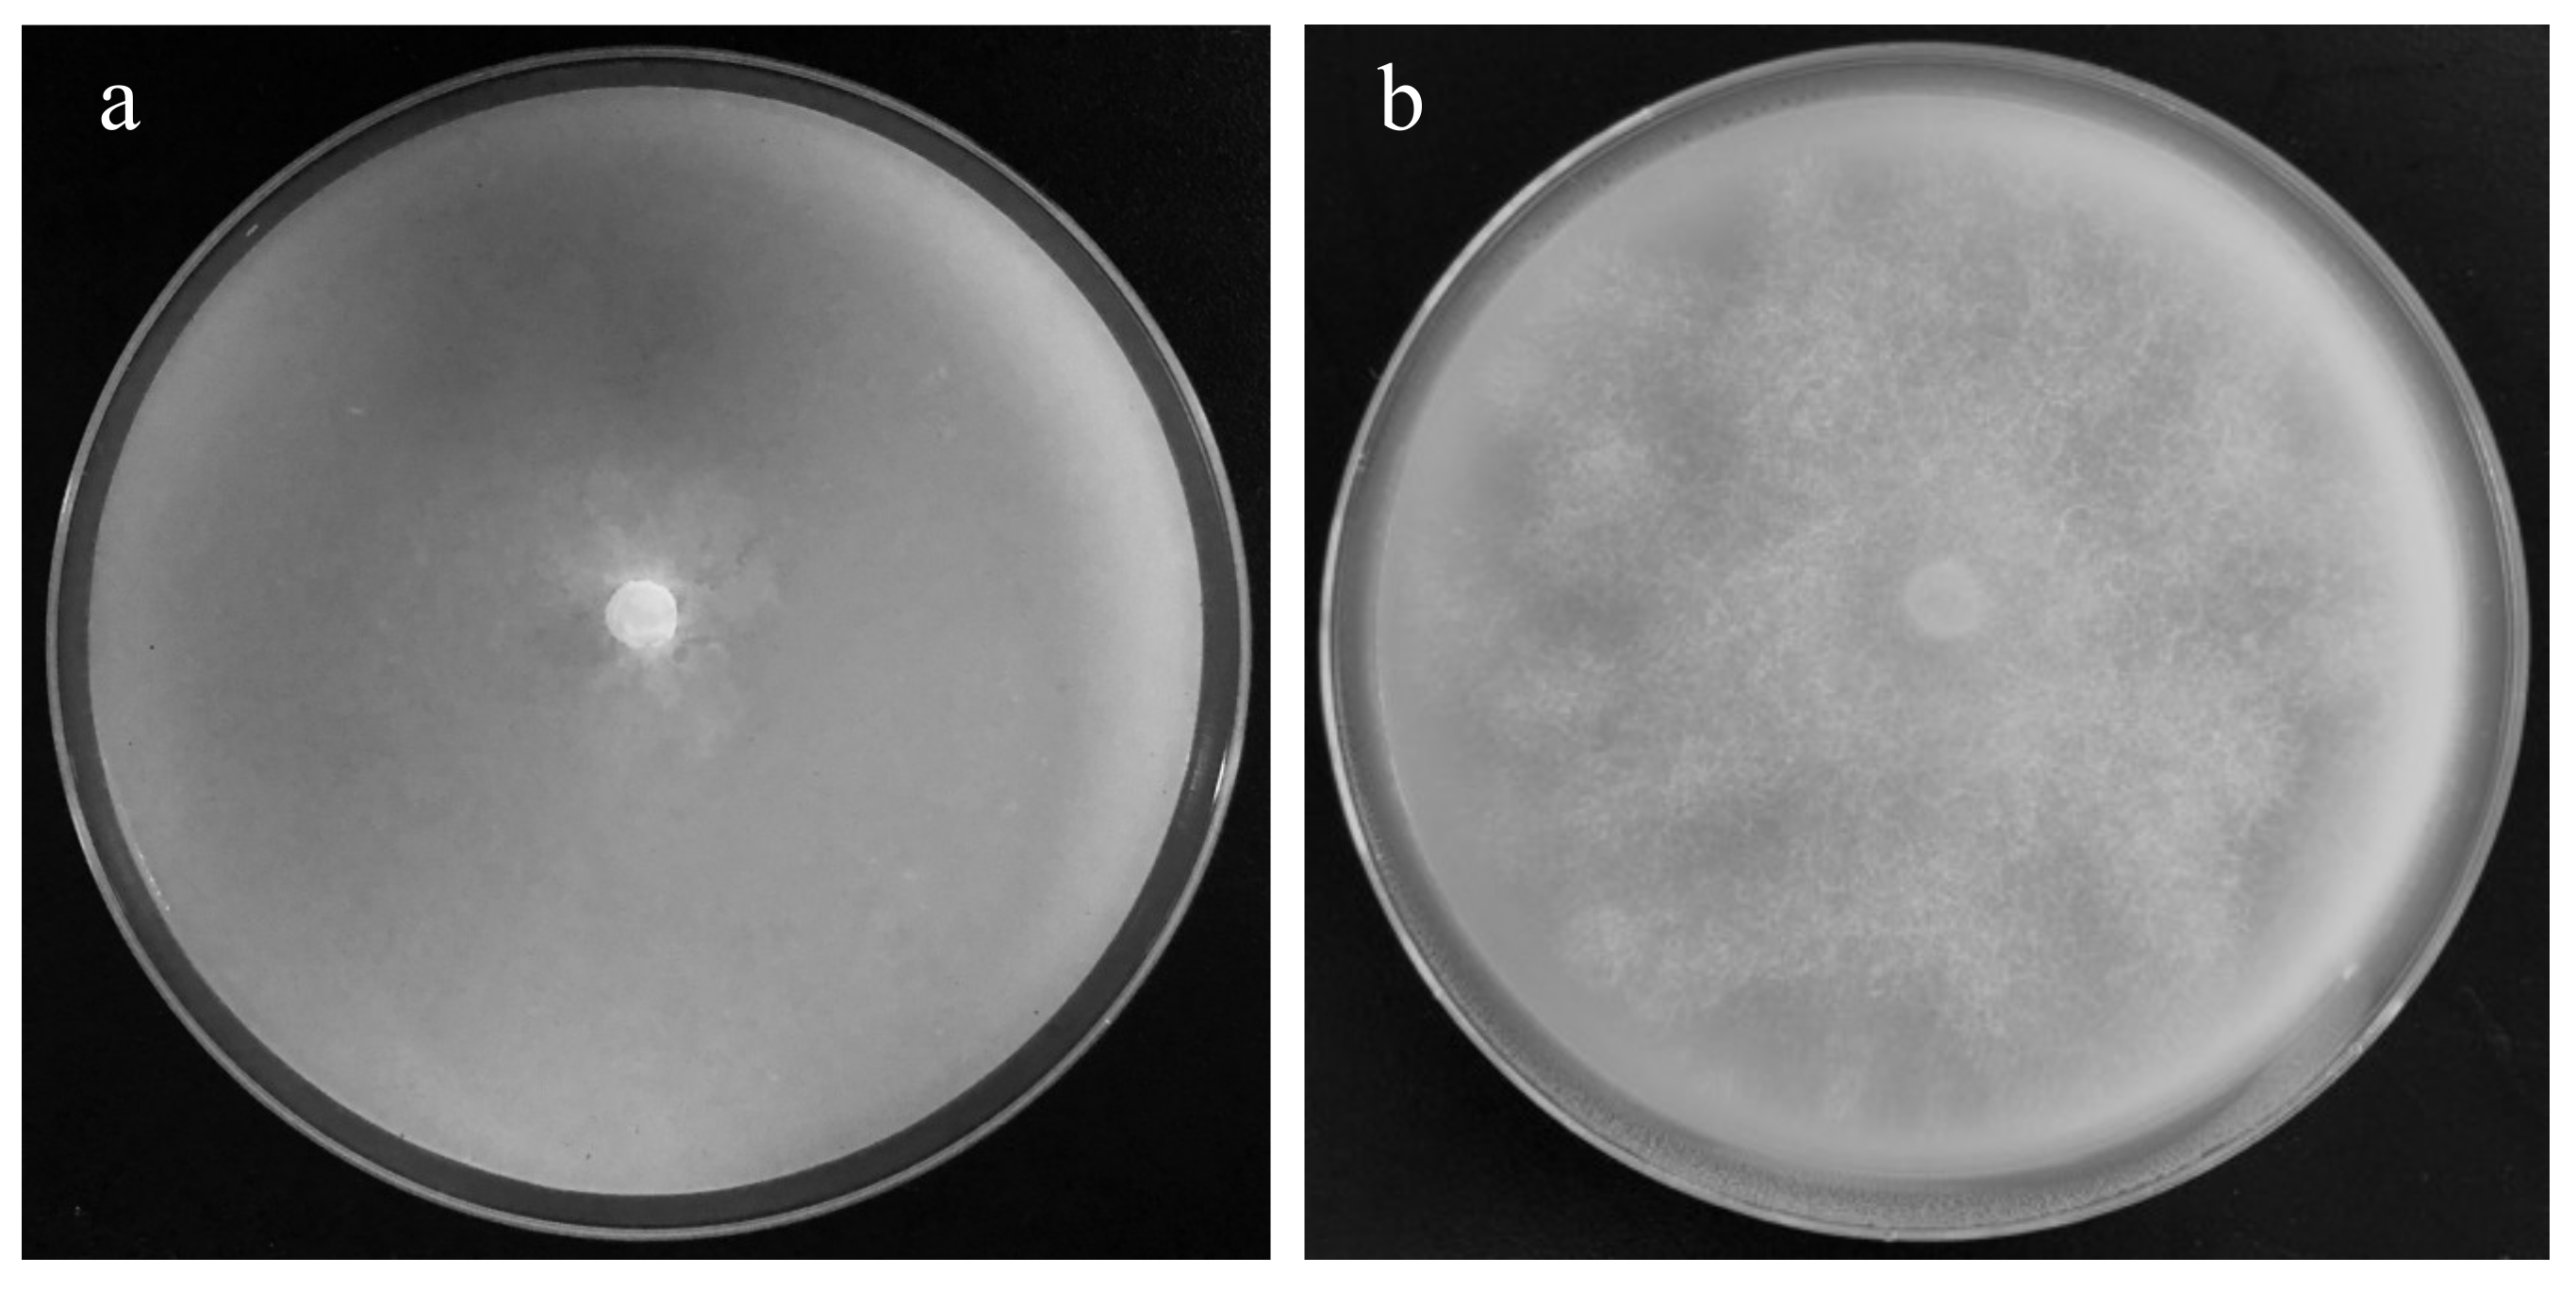
Applsci 11 07261 g001 Applsci 11 07261 g001

A Novel Bio-Fertilizer Produced by Prickly Ash Seeds with Biochar Addition Induces Soil Suppressiveness against Black Shank Disease on Tobacco
Abstract
1. Introduction
2. Materials and Methods
2.1. Materials
2.2. Optimization of PBB Production in Solid State Fermentation
2.3. Chemical Property Determination of PBB
2.4. Seed Germination Test for PBB
2.5. The Fumigation Inhibition Effect of PBB on P. nicotianae
2.6. Pot Experiment
2.7. Real-Time Fluorescent Quantitative PCR of P. nicotianae
2.8. Soil Chemical Property Determination
2.9. Microbial Diversity and Community of Rhizospheric Soil
2.10. Statistical Analysis
3. Results
3.1. PBB in Solid-State Fermentation
3.2. Biochemical Characteristics of PBB
3.3. Inhibition Effect of PBB on P. nicotianae
3.4. Prevention Effect of PBB Application on Tobacco Black Shank Disease
3.5. Soil Chemical Properties Affected by PBB Addition
3.6. Microbial Diversity and Richness of Rhizospheric Soil
3.7. Effect of BOF Addition on Soil Microbial Community Structure
3.8. Correlation between Soil Microbial Community and Soil Environmental Factors
4. Discussion
5. Conclusions
Supplementary Materials
Author Contributions
Funding
Conflicts of Interest
References
- Kong, P.; Hong, C.; Jeffers, S.N.; Richardson, P.A. A Species-Specific Polymerase Chain Reaction Assay for Rapid Detection of Phytophthora nicotianae in Irrigation Water. Phytopathology 2003, 93, 822–831. [Google Scholar] [CrossRef][Green Version]
- Panabières, F.; Ali, G.S.; Allagui, M.B.; Dalio, R.J.D.; Gudmestad, N.C.; Kuhn, M.L.; Guha, R.S.; Schena, L.; Zam-pounis, A. Phytophthora nicotianae diseases worldwide: New knowledge of a long-recognised pathogen. Phytopathol. Mediterr. 2016, 55, 20–40. [Google Scholar] [CrossRef]
- Wang, H.-C.; Chen, X.-J.; Cai, L.-T.; Cao, Y.; Lu, N.; Xia, H.-Q.; Wang, M.-S.; Shang, S.-H. Race distribution and distribution of sensitivities to mefenoxam among isolates of Phytophthora parasitica var. nicotianae in Guizhou province of China. Crop Prot. 2013, 52, 136–140. [Google Scholar] [CrossRef]
- Wang, Y.; Liu, M.; Han, X.; Zheng, Y.; Chao, J.; Zhang, C.-S. Prickly Ash Seed Kernel: A New Bio-Fumigation Material Against Tobacco Black Shank. Agronomy 2020, 10, 770. [Google Scholar] [CrossRef]
- Wang, X.; Shi, W.; Wang, J.; Gao, Z.; Li, S.; Wang, N.; Shi, Q. Control of Southern Root-knot Nematodes on Tomato and Regulation of Soil Bacterial Community by Biofumigation with Zanthoxylum bungeanum Seed. Hortic. Plant J. 2021, 7, 49–58. [Google Scholar] [CrossRef]
- Guo, X.-X.; Liu, H.-T.; Zhang, J. The role of biochar in organic waste composting and soil improvement: A review. Waste Manag. 2020, 102, 884–899. [Google Scholar] [CrossRef] [PubMed]
- Yang, Y.; Awasthi, M.K.; Bao, H.; Bie, J.; Lei, S.; Lv, J. Exploring the microbial mechanisms of organic matter transformation during pig manure composting amended with bean dregs and biochar. Bioresour. Technol. 2020, 313, 123647. [Google Scholar] [CrossRef]
- Mosharrof, M.; Uddin, K.; Sulaiman, M.; Mia, S.; Shamsuzzaman, S.; Haque, A. Combined Application of Biochar and Lime Increases Maize Yield and Accelerates Carbon Loss from an Acidic Soil. Agronomy 2021, 11, 1313. [Google Scholar] [CrossRef]
- Jaiswal, A.K.; Frenkel, O.; Tsechansky, L.; Elad, Y.; Graber, E.R. Immobilization and deactivation of pathogenic enzymes and toxic metabolites by biochar: A possible mechanism involved in soilborne disease suppression. Soil Biol. Biochem. 2018, 121, 59–66. [Google Scholar] [CrossRef]
- Xiong, W.; Guo, S.; Jousset, A.; Zhao, Q.; Wu, H.; Li, R.; Kowalchuk, G.A.; Shen, Q. Bio-fertilizer application induces soil suppressiveness against Fusarium wilt disease by reshaping the soil microbiome. Soil Biol. Biochem. 2017, 114, 238–247. [Google Scholar] [CrossRef]
- Wang, B.; Shen, Z.; Zhang, F.; Raza, W.; Yuan, J.; Huang, R.; Ruan, Y.; Li, R.; Shen, Q. Bacillus amyloliquefaciens Strain W19 can Promote Growth and Yield and Suppress Fusarium Wilt in Banana under Greenhouse and Field Conditions. Pedosphere 2016, 26, 733–744. [Google Scholar] [CrossRef]
- Bao, S. Soil Agrochemical Analysis; China Agriculture Press Co., Ltd.: Beijing, China, 2000. [Google Scholar]
- Zhang, C.; Gao, J.; Han, T.; Tian, X.; Wang, F. Integrated control of tobacco black shank by combined use of riboflavin and Bacillus subtilis strain Tpb55. BioControl 2017, 62, 835–845. [Google Scholar] [CrossRef]
- Liu, Y.; Shi, J.; Feng, Y.; Yang, X.; Li, X.; Shen, Q. Tobacco bacterial wilt can be biologically controlled by the application of antagonistic strains in combination with organic fertilizer. Biol. Fertil. Soils 2013, 49, 447–464. [Google Scholar] [CrossRef]
- Qiu, M.; Zhang, R.; Xue, C.; Zhang, S.; Li, S.; Zhang, N.; Shen, Q. Application of bio-organic fertilizer can control Fusarium wilt of cucumber plants by regulating microbial community of rhizosphere soil. Biol. Fertil. Soils 2012, 48, 807–816. [Google Scholar] [CrossRef]
- Zhao, J.; Wang, Y.; Liang, H.; Huang, J.; Chen, Z.; Nie, Y. The rhizosphere microbial community response to a bio-organic fertilizer: Finding the mechanisms behind the suppression of watermelon Fusarium wilt disease. Acta Physiol. Plant. 2018, 40, 17. [Google Scholar] [CrossRef]
- Xiao, R.; Awasthi, M.K.; Li, R.; Park, J.; Pensky, S.M.; Wang, Q.; Wang, J.J.; Zhang, Z. Recent developments in biochar utilization as an additive in organic solid waste composting: A review. Bioresour. Technol. 2017, 246, 203–213. [Google Scholar] [CrossRef]
- Huang, X.; Chen, L.; Ran, W.; Shen, Q.; Yang, X. Trichoderma harzianum strain SQR-T37 and its bio-organic fertilizer could control Rhizoctonia solani damping-off disease in cucumber seedlings mainly by the mycoparasitism. Appl. Microbiol. Biotechnol. 2011, 91, 741–755. [Google Scholar] [CrossRef] [PubMed]
- Lang, J.; Hu, J.; Ran, W.; Xu, Y.; Shen, Q. Control of cotton Verticillium wilt and fungal diversity of rhizosphere soils by bio-organic fertilizer. Biol. Fertil. Soils 2012, 48, 191–203. [Google Scholar] [CrossRef]
- Gao, C.; El-Sawah, A.M.; Ali, D.F.I.; Hamoud, Y.A.; Shaghaleh, H.; Sheteiwy, M.S. The Integration of Bio and Organic Fertilizers Improve Plant Growth, Grain Yield, Quality and Metabolism of Hybrid Maize (Zea mays L.). Agronomy 2020, 10, 319. [Google Scholar] [CrossRef]
- Hussain, A.; Zahir, Z.A.; Ditta, A.; Tahir, M.U.; Ahmad, M.; Mumtaz, M.Z.; Hayat, K.; Hussain, S. Production and implication of bio-activated organic fertilizer enriched with zinc-solubilizing bacteria to boost up maize (Zea mays L.) Production and Biofortification under Two Cropping Seasons. Agronomy 2020, 10, 39. [Google Scholar] [CrossRef]
- Chen, Y.; Xu, Y.; Zhou, T.; Akkaya, M.S.; Wang, L.; Li, S.; Li, X. Biocontrol of Fusarium wilt disease in strawberries using bioorganic fertilizer fortified with Bacillus licheniformis X-1 and Bacillus methylotrophicus Z-1. 3 Biotech 2020, 10, 80. [Google Scholar] [CrossRef]
- Hafez, M.; Popov, A.I.; Rashad, M. Integrated use of bio-organic fertilizers for enhancing soil fertility–plant nutrition, germination status and initial growth of corn (Zea mays L.). Environ. Technol. Innov. 2021, 21, 101329. [Google Scholar] [CrossRef]
- Faure, D.; Vereecke, D.; Leveau, J.H.J. Molecular communication in the rhizosphere. Plant Soil 2009, 321, 279–303. [Google Scholar] [CrossRef]
- Li, X.-G.; Ding, C.-F.; Zhang, T.-L.; Wang, X.-X. Fungal pathogen accumulation at the expense of plant-beneficial fungi as a consequence of consecutive peanut monoculturing. Soil Biol. Biochem. 2014, 72, 11–18. [Google Scholar] [CrossRef]
- Zheng, X.; Zhu, Y.; Wang, Z.; Zhang, H.; Chen, M.; Chen, Y.; Wang, J.; Liu, B. Effects of a novel bio-organic fertilizer on the composition of rhizobacterial communities and bacterial wilt outbreak in a continuously mono-cropped tomato field. Appl. Soil Ecol. 2020, 156, 103717. [Google Scholar] [CrossRef]
- Shen, Z.; Wang, D.; Ruan, Y.; Xue, C.; Zhang, J.; Li, R.; Shen, Q. Deep 16S rRNA Pyrosequencing Reveals a Bacterial Community Associated with Banana Fusarium Wilt Disease Suppression Induced by Bio-Organic Fertilizer Application. PLoS ONE 2014, 9, e98420. [Google Scholar] [CrossRef]
- Ziedan, E.-S.H.; Farrag, E.S.; Sahab, A. First record and preliminary evaluation ofMucor hiemalisas biocontrol agent on inflorescence brown rot incidence of date palm. Arch. Phytopathol. Plant Prot. 2013, 46, 617–626. [Google Scholar] [CrossRef]
- Cong, Y.; Fan, H.; Ma, Q.; Lu, Y.; Xu, L.; Zhang, P.; Chen, K. Mixed culture fermentation between Rhizopus nigricans and Trichoderma pseudokoningii to control cucumber Fusarium wilt. Crop. Prot. 2019, 124, 104857. [Google Scholar] [CrossRef]
- da Silva, M.N.; Pintado, M.M.; Sarmento, B.; Stamford, N.; Vasconcelos, M. A biofertilizer with diazotrophic bacteria and a filamentous fungus increases Pinus pinaster tolerance to the pinewood nematode (Bursaphelenchus xylophilus). Biol. Control. 2019, 132, 72–80. [Google Scholar] [CrossRef]
- Sharma, S.; Kumar, S.; Khajuria, A.; Ohri, P.; Kaur, R.; Kaur, R. Biocontrol potential of chitinases produced by newly isolated Chitinophaga sp. S167. World J. Microbiol. Biotechnol. 2020, 36, 1–15. [Google Scholar] [CrossRef] [PubMed]
- Ma, Y.; Rajkumar, M.; Oliveira, R.S.; Zhang, C.; Freitas, H. Potential of plant beneficial bacteria and arbuscular mycorrhizal fungi in phytoremediation of metal-contaminated saline soils. J. Hazard. Mater. 2019, 379, 120813. [Google Scholar] [CrossRef] [PubMed]

| Number | Orthogonal Treatment Design | pH (Day 0) | pH (Day 7) | Colony Density c (cfu/g) | ||
|---|---|---|---|---|---|---|
| PAS a (%) | >SP b (%) | >Biochar (%) | ||||
| 1 | 50 | 15 | 15 | 6.33 ± 0.00 e | 6.82 ± 0.01 d | 8 × 108 d |
| 2 | 50 | 10 | 30 | 6.54 ± 0.00 b | 6.93 ± 0.01 b | 5 × 108 d |
| 3 | 50 | 5 | 45 | 6.65 ± 0.01 a | 6.96 ± 0.01 b | 1.7 × 1010 a |
| 4 | 60 | 15 | 45 | 6.64 ± 0.00 a | 7.05 ± 0.01 a | 4.1 × 109 b |
| 5 | 60 | 10 | 15 | 6.39 ± 0.01 de | 7.02 ± 0.02 a | 5.9 × 109 b |
| 6 | 60 | 5 | 30 | 6.55 ± 0.00 b | 6.93 ± 0.00 b | 2.8 × 109 c |
| 7 | 70 | 15 | 30 | 6.52 ± 0.00 bc | 6.78 ± 0.02 e | 4.4 × 109 b |
| 8 | 70 | 10 | 15 | 6.37 ± 0.00 de | 6.87 ± 0.00 c | 2.4 × 109 c |
| 9 | 70 | 5 | 45 | 6.45 ± 0.09 cd | 6.89 ± 0.02 c | 1.6 × 1010 a |
| 10 | 0 | 100 | 0 | 6.38 ± 0.02 de | 6.12 ± 0.02 g | 1.4 × 1010 a |
| 11 | 100 | 0 | 0 | 6.13 ± 0.01 f | 6.17 ± 0.01 f | 1.8 × 104 e |
| Treatment | DNA Copies of P. nicotianae | Disease Index | |
|---|---|---|---|
| Fifth Day | Fifteenth Day | Fifteenth Day | |
| PBB4 | 3494.31 ± 85.77 d | 3346.10 ± 95.92 d | 25.93 ± 2.21 c |
| PBB2 | 277,980.00 ± 1346.43 c | 14,717.10 ± 174.78 d | 40.74 ± 2.45 b |
| CK | 1,312,089.77 ± 5765.04 a | 1,388,622.37 ± 12,616.09 a | 63.89 ± 2.07 a |
| Treatment | pH | Electrical Conductivity (μs/cm) | Available P (mg/kg) | Available K (mg/kg) | Hydrolysable N (mg/kg) | Organic Carbon (g/kg) |
|---|---|---|---|---|---|---|
| PBB4 | 6.79 ± 0.02 a | 677.00 ± 4.36 c | 72.76 ± 1.41 b | 847.31 ± 3.30 a | 357.39 ± 5.66 a | 102.09 ± 0.39 a |
| PBB2 | 6.56 ± 0.00 b | 793.00 ± 12.17 b | 80.86 ± 1.29 a | 696.60 ± 3.35 b | 301.52 ± 38.82 b | 102.77 ± 2.29 a |
| CK | 6.19 ± 0.03 c | 1148.33 ± 103.00 a | 72.75 ± 0.16 b | 462.22 ± 3.31 c | 288.63 ± 10.90 b | 69.82 ± 3.57 b |
| Treatment | Fungal Community | Bacterial Community | ||||||
|---|---|---|---|---|---|---|---|---|
| OTUs | Shannon | Chao1 | ACE | OTUs | Shannon | Chao1 | ACE | |
| Control | 207 ± 11 a | 2.78 ± 0.09 a | 235 ± 12 a | 237 ± 11 a | 1474 ± 119 a | 7.50 ± 0.28 a | 1612 ± 110 a | 1637 ± 105 a |
| PBB | 138 ± 6 b | 2.53 ± 0.07 b | 160 ± 15 b | 177 ± 20 b | 1362 ± 38ab | 7.07 ± 0.27 a | 1517 ± 24 a | 1534 ± 26 a |
| Category | Genus | Relative Abundance (%) | |
|---|---|---|---|
| 4% PBB Addition | Control | ||
| Fungi | Mucor | 28.8 ± 3.60 a | 2.83 ± 0.55 b |
| Rhizopus | 30.41 ± 2.26 a | 0. 76 ± 0.12 b | |
| Penicillium | 3.41 ± 0.62 b | 23.13 ± 1.27 a | |
| Trichoderma | 2.32 ± 0.40 b | 6.94 ± 0.66 a | |
| Fusarium | 0.12 ± 0.03 b | 0.79 ± 0.08 a | |
| Cunninghamella | 0.41 ± 0.001 a | 0.00 ± 0. 01 b | |
| Serendipita | 0.00 ± 0.00 b | 0.11 ± 0.01 a | |
| Arthrobotrys | 0.00 ± 0.00 b | 0.08 ± 0.002 a | |
| Helvella | 0.00 ± 0.001 b | 0.03 ± 0.0001 a | |
| Bacteria | Chitinophaga | 11.77 ± 0.03 a | 1.95 ± 0.39 b |
| Sphingomonas | 0.04 ± 0.002 b | 0.09 ± 0.003 a | |
| Chitinophagaceae | 1.14 ± 0.03 b | 0.06 ± 0.01 a | |
| Dyella | 2.54 ± 0.01 a | 1.93 ± 0.12 b | |
| Rhodanobacter | 1.24 ± 0.31 b | 4.24 ± 0.43 a | |
| Phenylobacterium | 3.51 ± 0.73 a | 1.64 ± 0.175 b | |
| Bacillus | 4.07 ± 0.43 a | 2.86 ± 0.24 b | |
| Gemmatimonas | 0.89 ± 0.16 b | 2.81 ± 0.72 a | |
Publisher’s Note: MDPI stays neutral with regard to jurisdictional claims in published maps and institutional affiliations. |
© 2021 by the authors. Licensee MDPI, Basel, Switzerland. This article is an open access article distributed under the terms and conditions of the Creative Commons Attribution (CC BY) license (https://creativecommons.org/licenses/by/4.0/).
Share and Cite
Zhang, X.; Wang, Y.; Han, X.; Gou, J.; Li, W.; Zhang, C. A Novel Bio-Fertilizer Produced by Prickly Ash Seeds with Biochar Addition Induces Soil Suppressiveness against Black Shank Disease on Tobacco. Appl. Sci. 2021, 11, 7261. https://doi.org/10.3390/app11167261
Zhang X, Wang Y, Han X, Gou J, Li W, Zhang C. A Novel Bio-Fertilizer Produced by Prickly Ash Seeds with Biochar Addition Induces Soil Suppressiveness against Black Shank Disease on Tobacco. Applied Sciences. 2021; 11(16):7261. https://doi.org/10.3390/app11167261
Chicago/Turabian StyleZhang, Xifen, Yaochen Wang, Xiaobin Han, Jianyu Gou, Wei Li, and Chengsheng Zhang. 2021. "A Novel Bio-Fertilizer Produced by Prickly Ash Seeds with Biochar Addition Induces Soil Suppressiveness against Black Shank Disease on Tobacco" Applied Sciences 11, no. 16: 7261. https://doi.org/10.3390/app11167261
APA StyleZhang, X., Wang, Y., Han, X., Gou, J., Li, W., & Zhang, C. (2021). A Novel Bio-Fertilizer Produced by Prickly Ash Seeds with Biochar Addition Induces Soil Suppressiveness against Black Shank Disease on Tobacco. Applied Sciences, 11(16), 7261. https://doi.org/10.3390/app11167261

